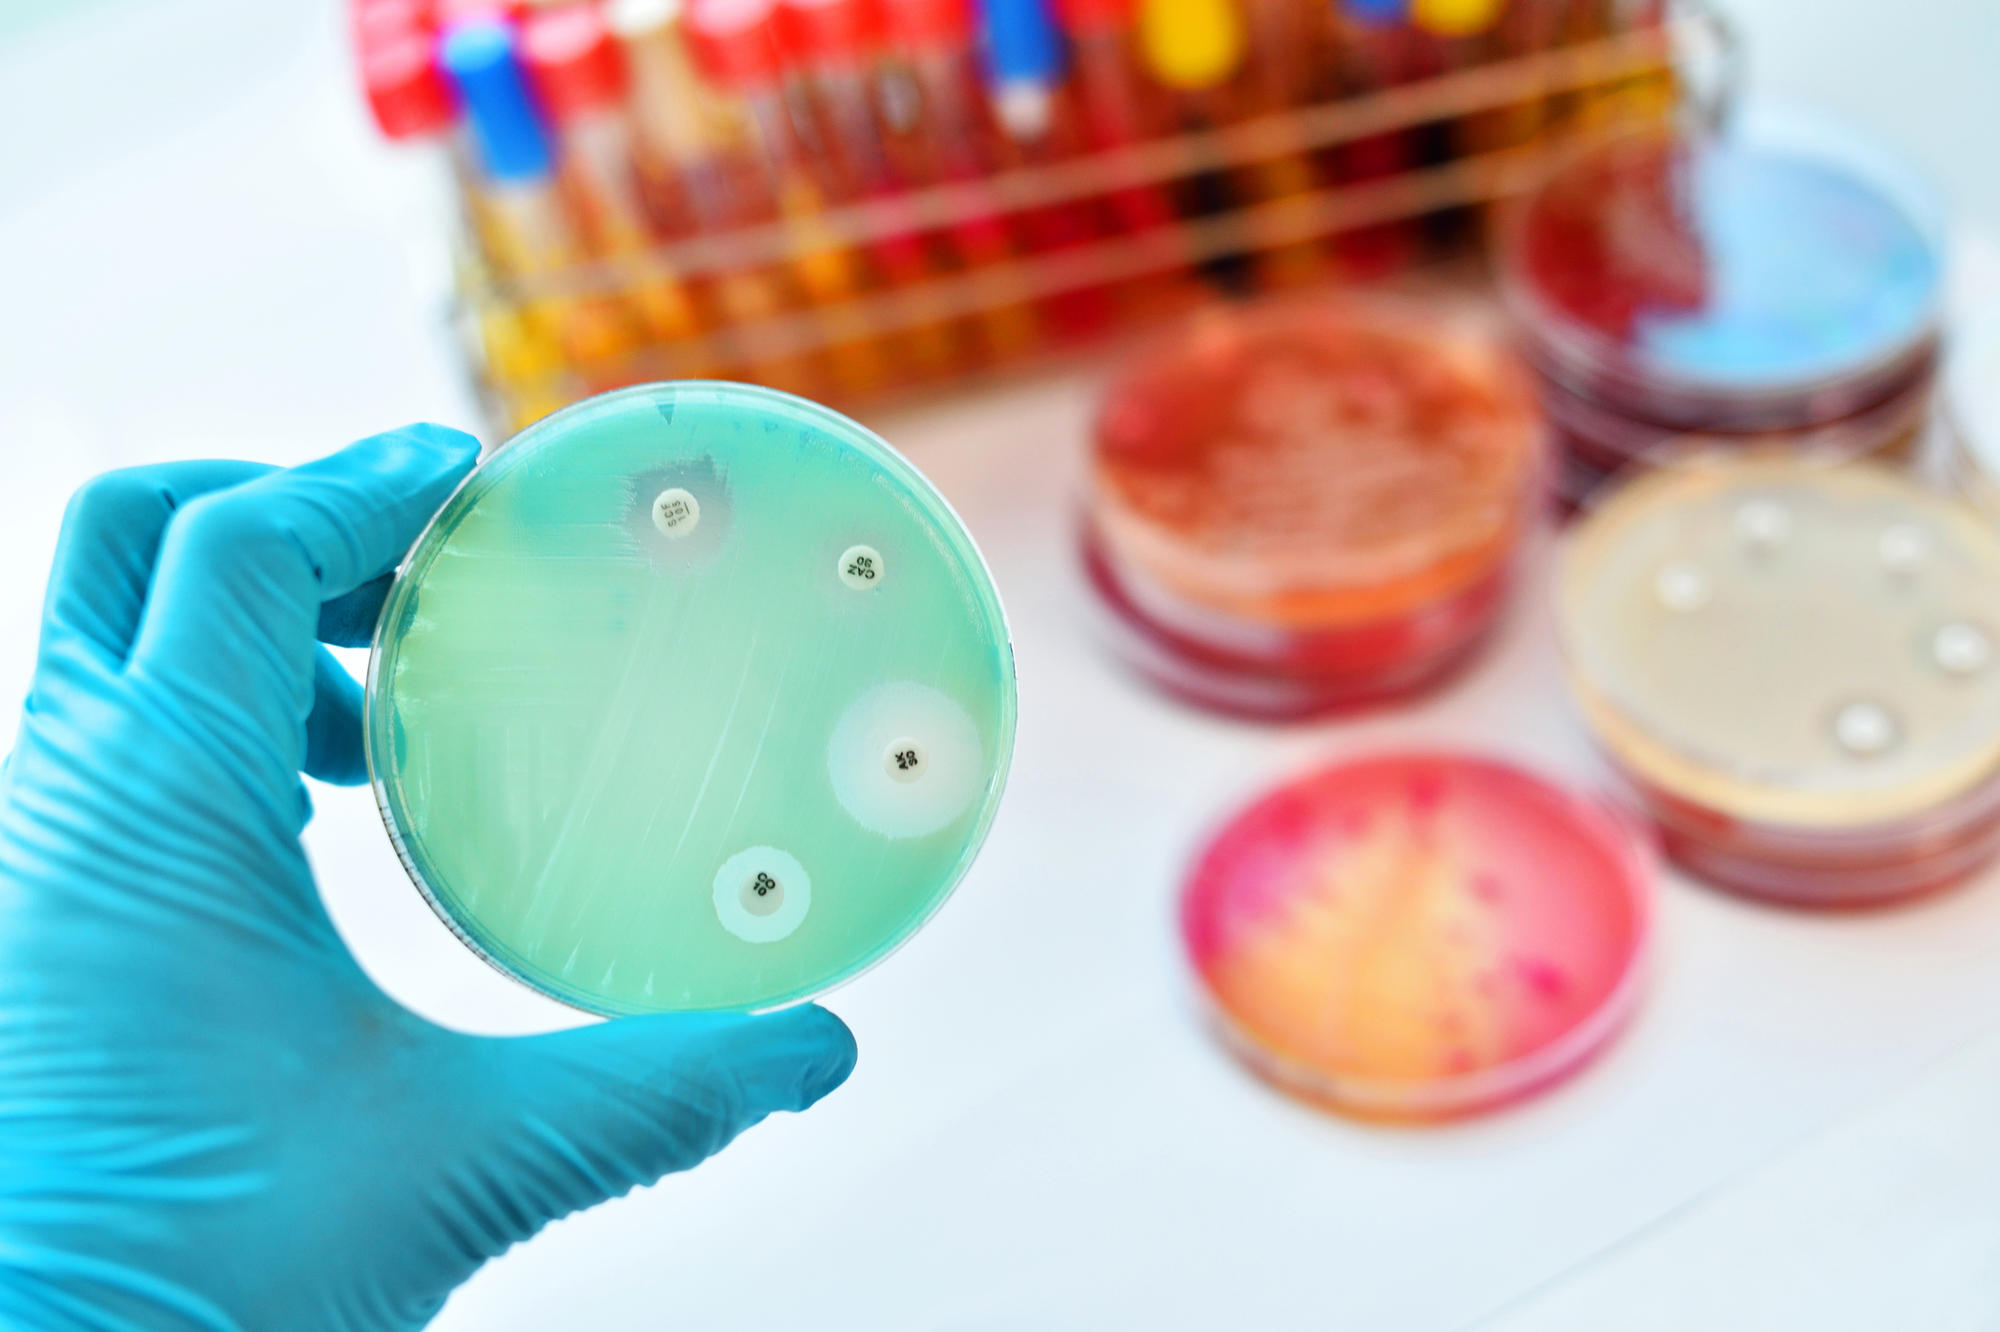
Wirksam: Auf einen grün eingefärbten Bakterienrasen sind vier Tropfen verschiedener Antibiotika aufgebracht worden. Der unterschiedlich breite weiße Ring zeigt, wie wirksam das Antibiotikum ist: An den weißen Stellen sind die Bakterien abgetötet.

Wirksam: Auf einen grün eingefärbten Bakterienrasen sind vier Tropfen verschiedener Antibiotika aufgebracht worden. Der unterschiedlich breite weiße Ring zeigt, wie wirksam das Antibiotikum ist: An den weißen Stellen sind die Bakterien abgetötet.
Bildquelle: istockphoto - R. Naylor